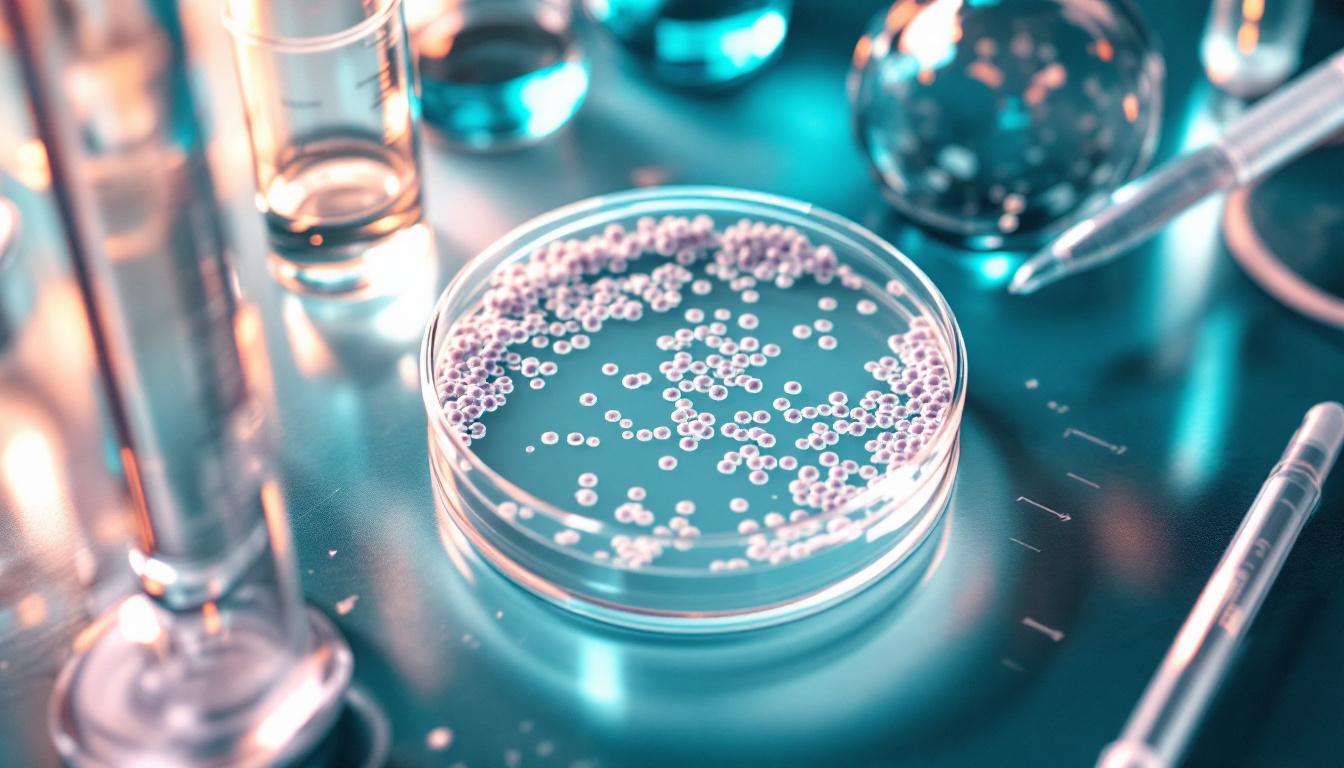
CFU Guide: Colony Forming Units 101

Medical Disclaimer: This article is for informational purposes only and does not constitute medical advice. Probiotic dosing should be based on strain-specific clinical evidence. Consult a healthcare provider before starting any probiotic regimen, particularly if you have underlying health conditions or take medications.
Introduction
Walk into any supplement aisle and you will find probiotic products boasting 30, 50, even 100 billion CFU — as though sheer numbers guarantee results. This "more is better" approach to probiotic marketing has created widespread confusion about how many colony forming units you actually need.
The truth is more nuanced. CFU count is just one factor in choosing an effective probiotic, and it is arguably less important than strain selection and clinical evidence. This guide explains what CFUs really mean, how to interpret them on labels, and what the science says about optimal dosing.
What Are Colony Forming Units?
CFU stands for Colony Forming Units — a standardized measurement of viable (living and capable of reproducing) microorganisms. When a lab technician places a sample on a growth medium, each viable organism multiplies to form a visible colony. The number of colonies formed indicates the number of viable organisms in the original sample.
On a probiotic label, the CFU count tells you how many live organisms the product should deliver per dose. A label stating "20 billion CFU" means each dose should contain 20 billion viable microorganisms.
CFU vs. Total Cell Count
Some newer products list "total cell count" or "AFU" (Active Fluorescent Units) instead of CFU. These methods count all cells — including those that are metabolically active but may not form colonies on traditional growth media. This is particularly relevant for organisms like Akkermansia muciniphila that are difficult to culture. For most traditional probiotic strains, CFU remains the standard measure.[1]
Why More CFU Is Not Always Better
One of the most persistent myths in probiotic marketing is that higher CFU counts are inherently superior. The evidence does not support this assumption.[2]
The Dose-Response Relationship Is Not Linear
A comprehensive review of probiotic dose-response studies found no consistent pattern showing that higher doses produce greater benefits.[2] In many cases, moderate doses (5–20 billion CFU) performed comparably to much higher doses. Some strains are clinically effective at just 1 billion CFU, while others may require higher counts depending on the health outcome being targeted.
Strain Specificity Matters More
Two probiotics at identical CFU counts can have completely different clinical effects if they contain different strains. A well-studied strain at 10 billion CFU — with clinical trial evidence for your specific health concern — is likely to be more effective than an unstudied strain at 100 billion CFU.[3]
For a detailed strain-by-strain breakdown, see our probiotic strain comparison chart. For a broader overview of probiotics, visit our probiotics guide.
Viability Through the GI Tract
A high CFU count at manufacture means little if the organisms do not survive to reach the gut. Factors affecting viability include:
- Stomach acid exposure: pH levels as low as 1.5–3.5 can kill many bacterial strains
- Bile salt exposure: In the small intestine, bile can further reduce viability
- Shelf stability: CFU counts decline over time, especially without proper storage
- Delivery format: Enteric coating, delayed-release capsules, and microencapsulation may improve survival
This is why reputable manufacturers guarantee CFU count through the expiration date — not just at time of manufacture, when counts are naturally highest.[1]
Recommended CFU Ranges by Health Goal
The following ranges are based on doses used in clinical trials. Individual needs may vary, and these are not prescriptive recommendations.
General Wellness and Microbiome Support
- Range: 5–20 billion CFU daily
- Context: For individuals without specific health concerns who want to support gut microbiome diversity. Most general wellness studies use this range.
Antibiotic-Associated Diarrhea Prevention
- Range: 10–20 billion CFU daily (strain-dependent)
- Key strains: Saccharomyces boulardii CNCM I-745 (5–10 billion CFU), Lactobacillus rhamnosus GG (10–20 billion CFU)
- Timing: Begin with the first antibiotic dose and continue for 1–2 weeks after antibiotics end[5]
Irritable Bowel Syndrome (IBS)
- Range: 1–20 billion CFU daily (highly strain-dependent)
- Key strains: Bifidobacterium longum 35624 (1 billion CFU), Lactobacillus plantarum 299v (10–20 billion CFU)
- Note: For IBS, the specific strain appears to matter more than the CFU count[6]
Immune Support
- Range: 1–10 billion CFU daily
- Key strains: L. rhamnosus GG, B. animalis subsp. lactis BB-12
- Context: Studies in children and elderly populations have used moderate doses with positive results
Acute Infectious Diarrhea
- Range: 10–50 billion CFU daily
- Context: Higher doses may be appropriate for acute situations, though evidence is strain-specific
Constipation
- Range: 1–20 billion CFU daily
- Key strains: B. animalis subsp. lactis BB-12, B. animalis subsp. lactis HN019
- Note: Some studies suggest that for constipation, the dose-response curve plateaus at moderate levels
How to Read a Probiotic Label: CFU Checklist
When evaluating a probiotic product, look for these CFU-related details:
- CFU count guaranteed at expiration — not "at time of manufacture"
- Specific strain designations — genus, species, AND strain (e.g., L. rhamnosus GG, not just "Lactobacillus")
- CFU per strain in multi-strain products — some products list total CFU but load up on cheaper strains
- Storage requirements — refrigerated products may have better viability; shelf-stable formulations should specify appropriate conditions
- Third-party verification — USP, NSF, or ConsumerLab certification helps verify label accuracy
Red Flags on Probiotic Labels
- CFU guaranteed only "at time of manufacture"
- No strain designations listed
- Proprietary blends that hide individual strain amounts
- Implausibly high CFU counts (200+ billion) without clinical justification
- Health claims that are not supported by strain-specific research
CFU Count and Side Effects
Higher CFU counts may increase the likelihood of initial side effects, particularly:
- Gas and bloating: Often temporary and subsides within 1–2 weeks
- Changes in stool consistency: May occur as the gut adjusts
- Abdominal discomfort: More common with very high doses
If you experience significant discomfort, consider:
- Reducing the dose and increasing gradually over 1–2 weeks
- Taking the probiotic with food to buffer stomach acid
- Switching to a different strain if symptoms persist[4]
Special Populations
Children
Pediatric probiotic doses are generally lower than adult doses — typically 1–10 billion CFU for most studied strains. Always use strains with pediatric safety data and consult a pediatrician.
Elderly
Older adults may benefit from moderate doses (5–20 billion CFU) of well-studied strains. Age-related changes in gut pH and transit time may affect probiotic viability.
Immunocompromised Individuals
People with compromised immune systems should consult a physician before taking any probiotic, regardless of CFU count. Rare cases of bacteremia and fungemia have been reported in critically ill patients.[4]
The Bottom Line
CFU count is a useful measure of probiotic viability, but it should not be the primary factor driving your purchasing decision. The most important considerations are:
- Strain selection — choose strains with clinical evidence for your specific health goal
- Appropriate dose — based on what was used in successful clinical trials for that strain
- Viability guarantee — CFU count guaranteed through expiration, not just at manufacture
- Product quality — third-party testing and proper storage
A thoughtfully chosen probiotic at 10 billion CFU will likely serve you far better than a random 100-billion-CFU product with unverified strains. Quality and evidence outweigh quantity.
References
- Hill C, Guarner F, Reid G, et al. The International Scientific Association for Probiotics and Prebiotics consensus statement on the scope and appropriate use of the term probiotic. Nat Rev Gastroenterol Hepatol. 2014;11(8):506-514.
- Ouwehand AC. A review of dose-responses of probiotics in human studies. Beneficial Microbes. 2017;8(2):143-151.
- Suez J, Zmora N, Segal E, Elinav E. The pros, cons, and many unknowns of probiotics. Nat Med. 2019;25(5):716-729.
- Sanders ME, Akkermans LMA, Haller D, et al. Safety assessment of probiotics for human use. Gut Microbes. 2010;1(3):164-185.
- Goldenberg JZ, Yap C, Lytvyn L, et al. Probiotics for the prevention of Clostridium difficile-associated diarrhea. Cochrane Database Syst Rev. 2017;12:CD006095.
- Ford AC, Quigley EMM, Lacy BE, et al. Efficacy of prebiotics, probiotics, and synbiotics in irritable bowel syndrome. Am J Gastroenterol. 2014;109(10):1547-1561.
Frequently Asked Questions
What does CFU mean on a probiotic label?
CFU stands for Colony Forming Units. It is a measurement of the number of viable (alive and capable of reproducing) microorganisms in a probiotic product. A product labeled '10 billion CFU' should contain 10 billion live organisms per dose that can form colonies when cultured in a lab setting. CFU counts should ideally be guaranteed through the expiration date, not just at the time of manufacture.
Is 50 billion CFU too much?
Not necessarily, but more is not always better. Most clinical trials showing health benefits use doses between 1 billion and 50 billion CFU. Higher doses (50–100+ billion) may be appropriate for specific therapeutic purposes but can also cause more gas, bloating, or digestive discomfort in some individuals. The right dose depends on the strain, the health goal, and individual tolerance. Starting lower and increasing gradually is generally a prudent approach.
Do higher CFU probiotics work better?
Not always. The relationship between CFU count and efficacy is not linear. Some strains are effective at 1 billion CFU, while others require higher doses. The specific strain, its viability through the digestive tract, and its match to your health goal matter more than raw CFU numbers. A well-researched strain at 10 billion CFU will likely outperform an unstudied strain at 100 billion CFU.
How many CFU should I take daily?
The optimal CFU count depends on the probiotic strain and your health goal. General wellness: 5–20 billion CFU is a common range. Antibiotic-associated diarrhea: 10–20 billion CFU of studied strains. IBS: 1–20 billion CFU depending on strain. Immune support: 1–10 billion CFU. Always follow the dosing used in clinical research for your specific strain and condition, and consult a healthcare provider for personalized guidance.
Do probiotics survive stomach acid?
Survival varies significantly by strain. Some strains, particularly spore-forming bacteria like Bacillus species and the yeast Saccharomyces boulardii, survive stomach acid well. Many Lactobacillus and Bifidobacterium strains are more vulnerable, which is why some products use enteric coating or delayed-release capsules. Taking probiotics with food may also buffer stomach acid and improve survival, though this varies by product.
References
- Hill C, Guarner F, Reid G, et al.. The International Scientific Association for Probiotics and Prebiotics consensus statement on the scope and appropriate use of the term probiotic. Nature Reviews Gastroenterology & Hepatology. 2014;11(8):506-514. doi:10.1038/nrgastro.2014.66
- Ouwehand AC. A review of dose-responses of probiotics in human studies. Beneficial Microbes. 2017;8(2):143-151. doi:10.3920/BM2016.0140
- Suez J, Zmora N, Segal E, Elinav E. The pros, cons, and many unknowns of probiotics. Nature Medicine. 2019;25(5):716-729. doi:10.1038/s41591-019-0439-x
- Sanders ME, Akkermans LMA, Haller D, et al.. Safety assessment of probiotics for human use. Gut Microbes. 2010;1(3):164-185. doi:10.4161/gmic.1.3.12127
- Goldenberg JZ, Yap C, Lytvyn L, et al.. Probiotics for the prevention of Clostridium difficile-associated diarrhea in adults and children. Cochrane Database of Systematic Reviews. 2017;12:CD006095. doi:10.1002/14651858.CD006095.pub4
- Ford AC, Quigley EMM, Lacy BE, et al.. Efficacy of prebiotics, probiotics, and synbiotics in irritable bowel syndrome and chronic idiopathic constipation. American Journal of Gastroenterology. 2014;109(10):1547-1561. doi:10.1038/ajg.2014.202